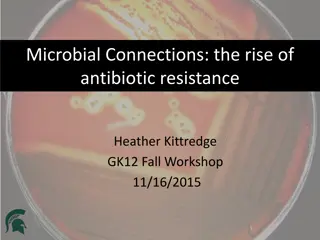

Antibiotic Susceptibility Testing
Antibiotic susceptibility testing is crucial in determining the effectiveness of antibiotics against specific bacteria. The Kirby-Bauer method, a standardized paper disk agar diffusion method, is commonly used for this purpose. By observing zones of inhibition around antibiotic disks on agar plates, one can assess bacterial sensitivity/resistance to various antibiotics. Factors influencing the zone of inhibition include growth medium, cation content, antimicrobial concentration, inoculum concentration, temperature, and atmosphere of incubation. Interpretation of zone sizes helps categorize organisms as resistant, intermediate, or sensitive to specific antibiotics.
Download Presentation

Please find below an Image/Link to download the presentation.
The content on the website is provided AS IS for your information and personal use only. It may not be sold, licensed, or shared on other websites without obtaining consent from the author.If you encounter any issues during the download, it is possible that the publisher has removed the file from their server.
You are allowed to download the files provided on this website for personal or commercial use, subject to the condition that they are used lawfully. All files are the property of their respective owners.
The content on the website is provided AS IS for your information and personal use only. It may not be sold, licensed, or shared on other websites without obtaining consent from the author.
E N D
Presentation Transcript
Practical No. 8 Antibiotic susceptibility testing
The method of testing most frequently used is the standardized paper disk agar diffusion method, also known as the Kirby-Bauer method. A number of small sterile filter disk of uniform size that have each been impregnated with an antibiotic in defined concentration are placed on the surface of an agar plate previously seeded with a standard amount of the organism to be tested.
Diffusion methods Kirby-Bauer method or disk diffusion antibiotic sensitivity testing: Small filter paper disks containing antibiotics are placed onto a plate upon which bacteria are growing. The antibiotic diffuses from the disk into the agar . If the bacteria are sensitive to the antibiotic, a clear ring, or zone of inhibition, is seen around the disk indicating poor growth. Using special comparators that interpret the diameter of the zones of inhibition, consequently the organism can be described as resistant, intermediate, or sensitive. Tables are used to determine the breakpoint for each drug.
The zone of inhibition around the antibiotic disk is influenced by the: (1) type of growth medium (2) its cation content (3) the antimicrobial concentration in the disk (4) inoculum concentration (5) temperature of incubation (6) atmosphere of incubation . N.T: Antibiotic disk may be single disks or strips of multiple antibiotic disks.
When the disks are in firm contact with the agar, their antibiotics diffuse into the surrounding medium and there come in contact with the multiplying organisms. The plates are incubated at 35oc for 18-24 hours. After incubation, the plates are examined for the presence of zones of inhibition of bacterial growth (clear rings) around the antibacterial disks. If there is no inhibition, the organism is reported as resistant (R) to the antibiotic in the disks. If there is inhibit a zone of inhibition surrounding the antibiotic disk, the organism is not susceptible (s) to the drug being tested.
Kirby-Bauer method for determining drug susceptibility Bacteria spread on surface of agar plate 12 disks, each with different antimicrobial drug, placed on agar plate Incubated- drugs diffuse outward and kill susceptible bacteria Zone of inhibition around each disk Compare size of zone to chart 1. 2. 3. 4. 5.
Agar disk diffusion method procedure: 1. from a prepared bacterial suspension, dip a swab and seed the surface of an agar plate with the swab then rotate the plate through a 45 angle and streak the whole surface again, then rotate the plate another 90 and streak once more. Discard the swab in disinfectant. 2. Dip the tips of a forceps in 70% alcohol, flame rapidly and allow cooling. 3. Pick up an antibiotic disc with the forceps and place it on the agar surface, press the disk gently using the tips of the forceps. 4. Repeat with eight different antibiotic disks; make sure they are separated evenly from each other. 5. Invert plates and incubate at 37 C overnight.
The diameter for size with values listed in a standared chart. Table (1): Diameter of zone of inhibition (mm) Disk Antibiotics Concentration Resistant Intermediate susceptible Ampicillin* Cephalothin Chloramphenicol Genamicin Pencillin** Polymyxin B Sulfonamide Tetracycline 10ug 30ug 30ug 10ug 10U 300U 300ug 30ug 1.1 or less 14 or less 12 or less 12 or less 20 or less 8 or less 12 or less 14 or less 12-13 15-17 13-17 13-14 21-28 8-11 13-16 15-18 14 or more 18 or more 18 or more 15 or more 29 or more 12 or more 17 or more 19 or more * Zone sizes appropriate only when testing Gram-negative enteric organisms ** Zone sizes appropriate only when testing staphylococci.
The Epsilometer test (usually abbreviated Etest) is a laboratory test used to determine whether or not a bacterium is susceptible to an antibiotic. The Etest is basically an agar diffusion method. The Etest utilises a rectangular strip that has been impregnated with the drug to be studied. A lawn of bacteria is inoculated onto the surface an agar plate and the Etest strip is laid on top; the drug diffuses out into the agar, producing an exponential gradient of the drug to be tested. There is an exponential scale printed on the strip. After 24 hours of incubation, an elliptical zone of inhibition is produced and the point at which the ellipse meets the strip gives a reading for the (MIC) of the drug.
when two antimicrobial agents act at the same time on the same microbial population, the effect may be either indifference. 1+1= 1 addition. 1+1=2 synergism. 1+1= 3 antagonism 1+1= 1/2
MIC (Minimum inhibitory concentration): MIC is the lowest concentration of an antimicrobial that will inhibit the visible growth of a microorganism after incubation. It is important in diagnostic laboratories to confirm resistance of micro organism to an antimicrobial agent. Also antimicrobial. to monitor the activity of new
Determinatrdion of MIC * Broth Tube Dilution method: - This test is the standard method for determining levels of resistance to an antibiotic. Serial dilutions of the antibiotic are made in a liquid medium which is inoculated with a standardized number of organisms and incubated for a 24 hours. The lowest concentration (highest dilution) of antibiotic preventing appearance of turbidity is the (MIC). At this dilution the antibiotic is bacterio static. The minimal bactericidal determined by sub culturing the contents of the tubes onto antibiotic-free solid medium and examining for bacterial growth. concentration (MBC)
Procedure of (MIC): 1. Number sterile capped test tubes 1 through 9. All of the following steps are carried out using aseptic technique. 2. Add 2.0 ml of tetracycline solution (100 ug/ml) to the first tube. Add 1.0 ml of sterile broth to all other tubes. 3. Transfer 1.0 ml from the first tube to the second tube. 4. Using a separate pipette, mix the contents of this tube and transfer 1.0 ml to the third tube. 5. Continue dilutions in this manner to tube number 8, being certain to change pipettes between tubes to prevent carryover of antibiotic on the external surface of the pipette. 6. Remove 1.0 ml from tube 8 and discard it. The ninth tube, which serves as a control, receives no tetracycline. 7. Suspend to an appropriate turbidity several colonies of the culture to be tested in 5.0 ml of Mueller-Hinton broth to give a slightly turbid suspension. 8. Dilute this suspension by aseptically pipetting 0.2 ml of the suspension into 40 ml of Mueller-Hinton broth. 9. Add 1.0 ml of the diluted culture suspension to each of the tubes. The final concentration of tetracycline is now one-half of the original concentration in each tube. 10. Incubate all tubes at 35oC overnight. 11. Examine tubes for visible signs of bacterial growth. The highest dilution without growth is the minimal inhibitory concentration (MIC).
Thank you Thank you